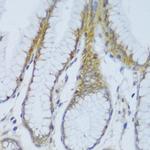
EFCAB4B Antibody in Immunohistochemistry (Paraffin) (IHC (P))

Search
Invitrogen
EFCAB4B Polyclonal Antibody
{{$productOrderCtrl.translations['antibody.pdp.commerceCard.promotion.promotions']}}
{{$productOrderCtrl.translations['antibody.pdp.commerceCard.promotion.viewpromo']}}
{{$productOrderCtrl.translations['antibody.pdp.commerceCard.promotion.promocode']}}: {{promo.promoCode}} {{promo.promoTitle}} {{promo.promoDescription}}. {{$productOrderCtrl.translations['antibody.pdp.commerceCard.promotion.learnmore']}}
图: 1 / 5
EFCAB4B Antibody (PA5-89473) in IHC (P)

Please note: We are reviewing Western blot images included in the antibody testing data in our catalog, including those provided by third parties. Unless expressly labeled or annotated as “raw-unedited”, Western blot images included in the antibody testing data in our catalog may have been edited, optimized or otherwise adjusted for presentation.
产品信息
PA5-89473
种属反应
宿主/亚型
分类
类型
抗原
偶联物
形式
浓度
规格
纯化类型
保存液
内含物
保存条件
运输条件
RRID
产品详细信息
Immunogen sequence: MAAPDGRVVS RPQRLGQGSG QGPKGSGACL HPLDSLEQKE TQEQTSGQLV MLRKAQEFFQ TCDAEGKGFI ARKDMQRLHK ELPLSLEELE DVFDALDADG NGYLTPQEFT TGFSHFFFSQ NNPSQEDAGE QVAQRHEEKV YLSRGDEDLG DMGEDEEAQF RMLMDRLGAQ KVLEDESDVK QLWLQLKKEE PHLLSNFEDF; Positive Samples: Mouse liver; Cellular Location: Cytoplasm
靶标信息
CRACR2A is a Ca(2+)-binding protein that plays a key role in store-operated Ca(2+) entry (SOCE) in T-cells by regulating CRAC channel activation. CRACR2A acts as a cytoplasmic calcium-sensor that facilitates the clustering of ORAI1 and STIM1 at the junctional regions between the plasma membrane and the endoplasmic reticulum upon low Ca(2+) concentration. Further, CRACR2A regulates CRAC channel activation, including translocation and clustering of ORAI1 and STIM1. Upon increase of cytoplasmic Ca(2+) resulting from opening of CRAC channels, CRACR2A dissociates from ORAI1 and STIM1, thereby destabilizing the ORAI1-STIM1 complex.
⚠WARNING: This product can expose you to chemicals including mercury, which is known to the State of California to cause birth defects or other reproductive harm. For more information go to www.P65Warnings.ca.gov.
仅用于科研。不用于诊断过程。未经明确授权不得转售。
篇参考文献 (0)
生物信息学
蛋白别名: Calcium release-activated channel regulator 2A; EF-hand calcium binding domain 4B; EF-hand calcium-binding domain-containing protein 4B; Ras-related protein Rab-46
基因别名: Cracr2a; Efcab4b; Gm1073; Gm462; Rab46
UniProt ID: (Mouse) Q3UP38
Entrez Gene ID: (Mouse) 381812




